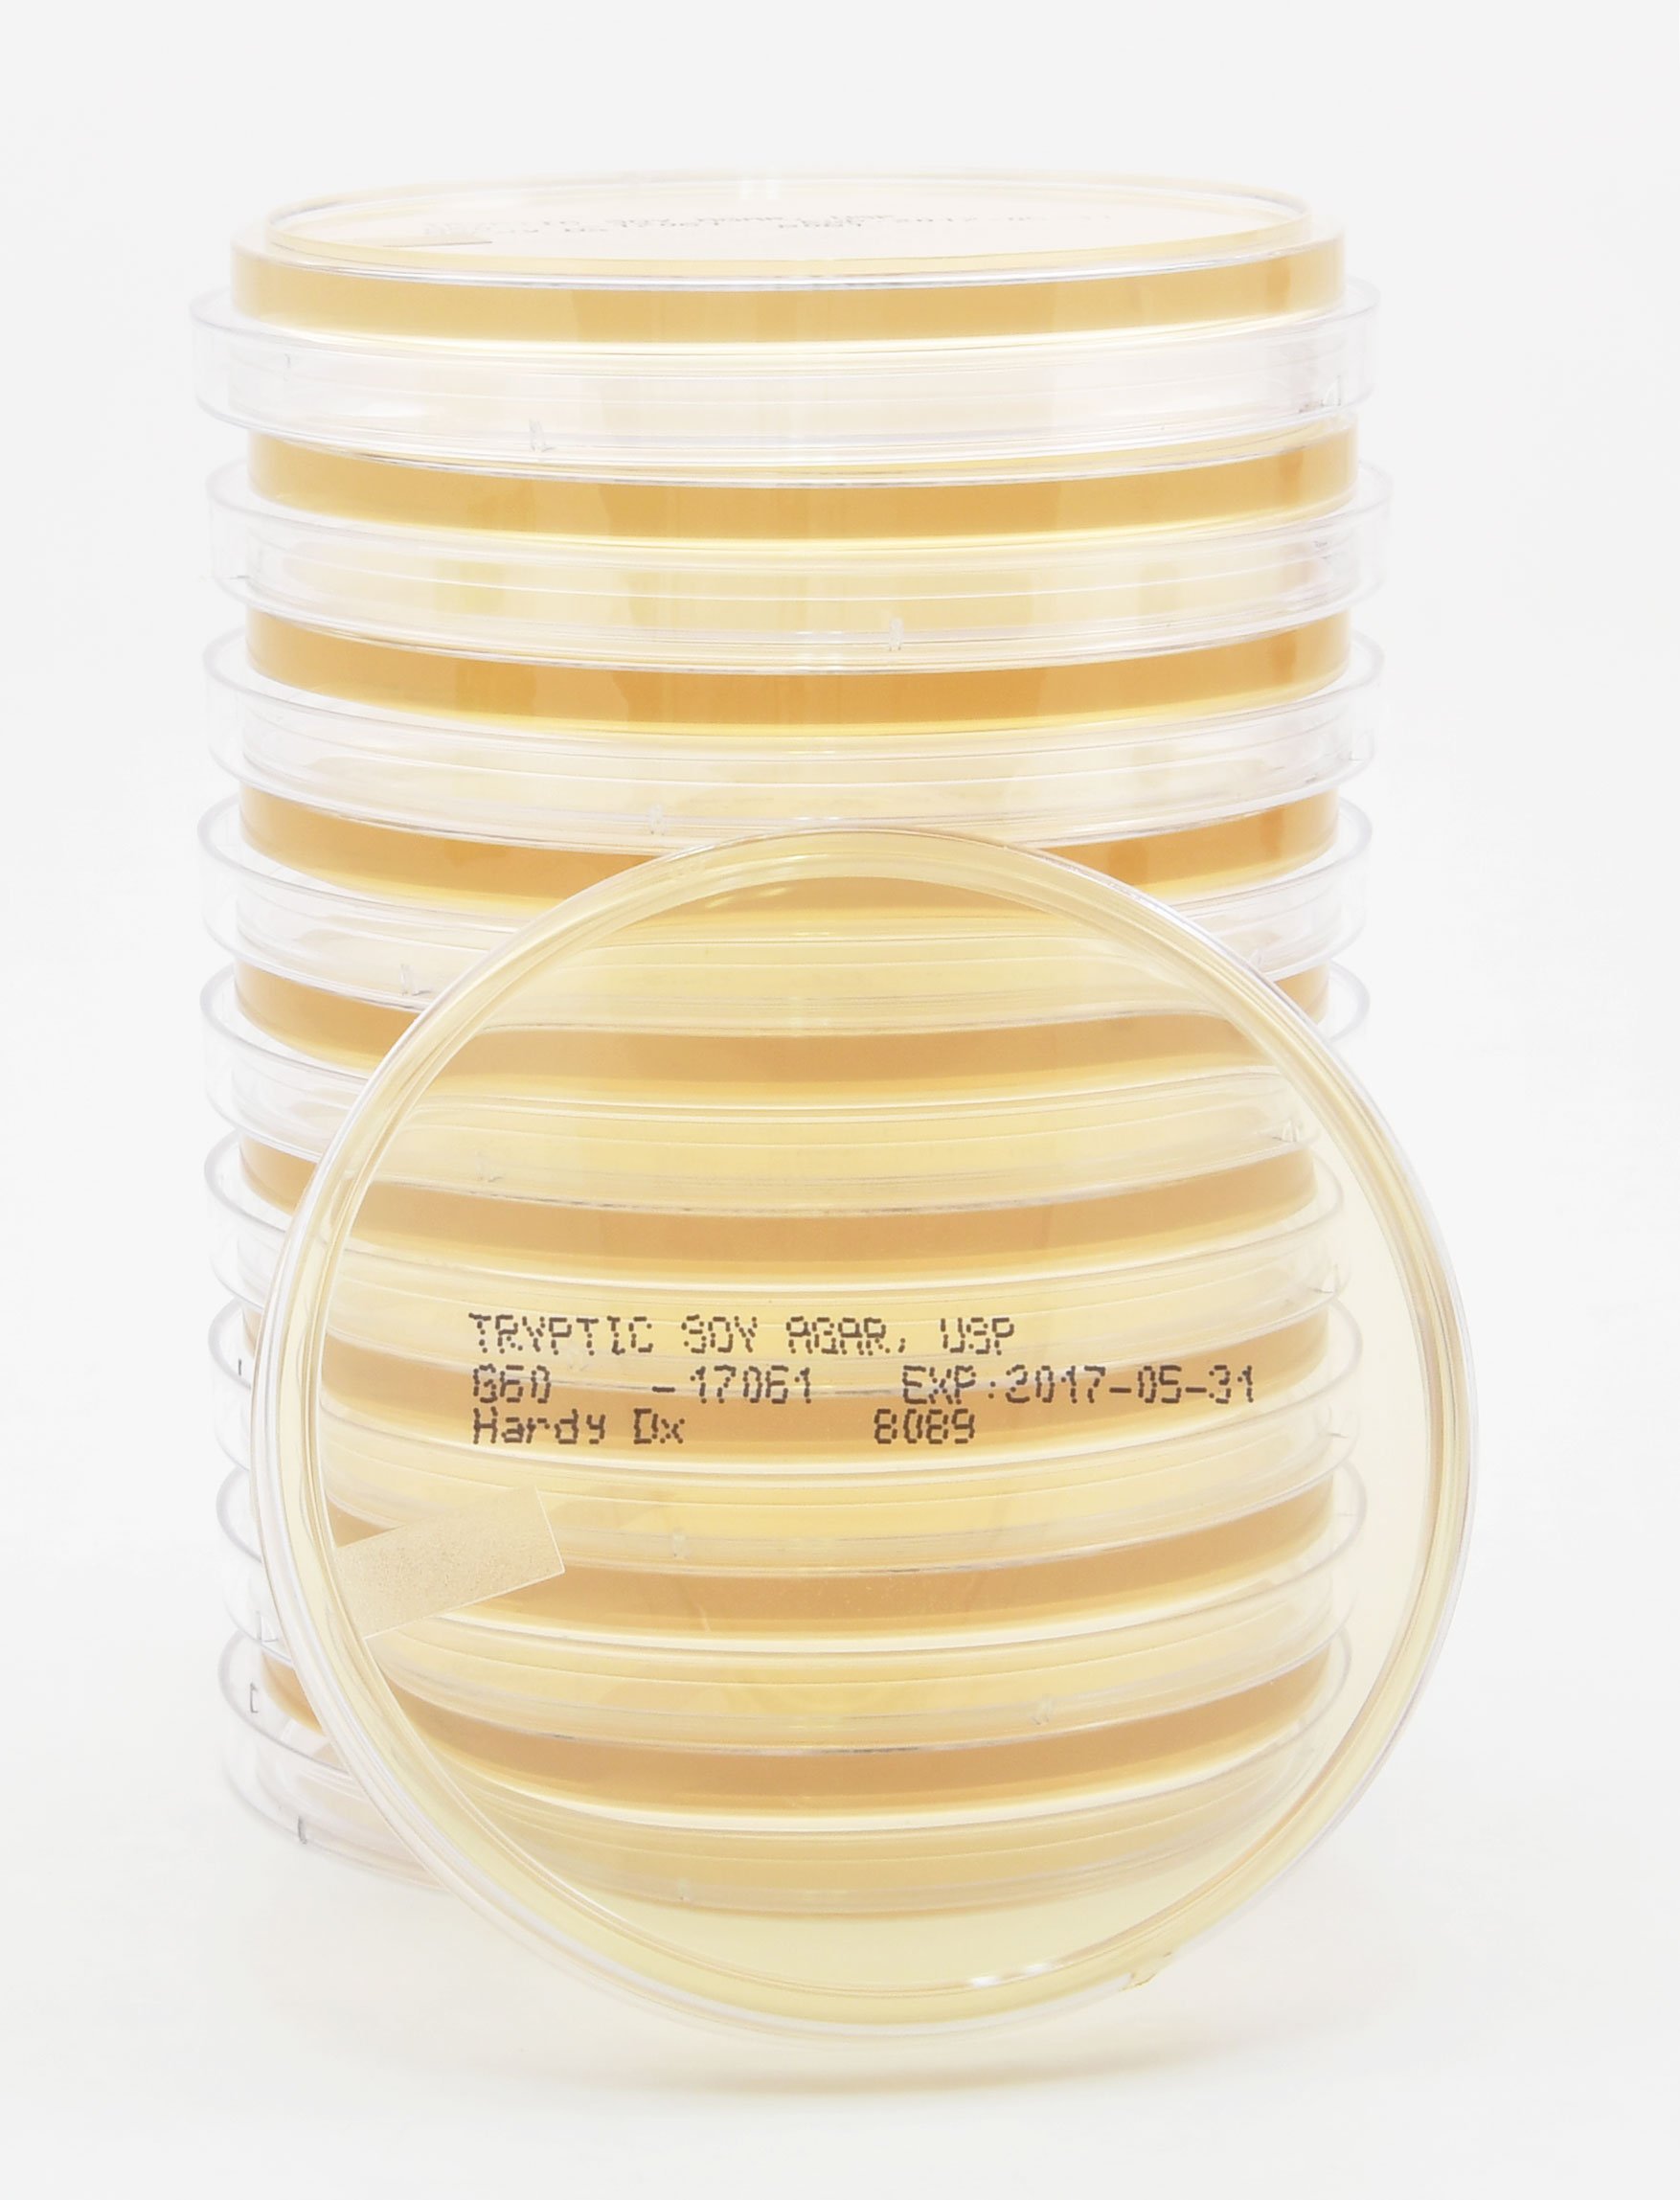
Thumbnail 3
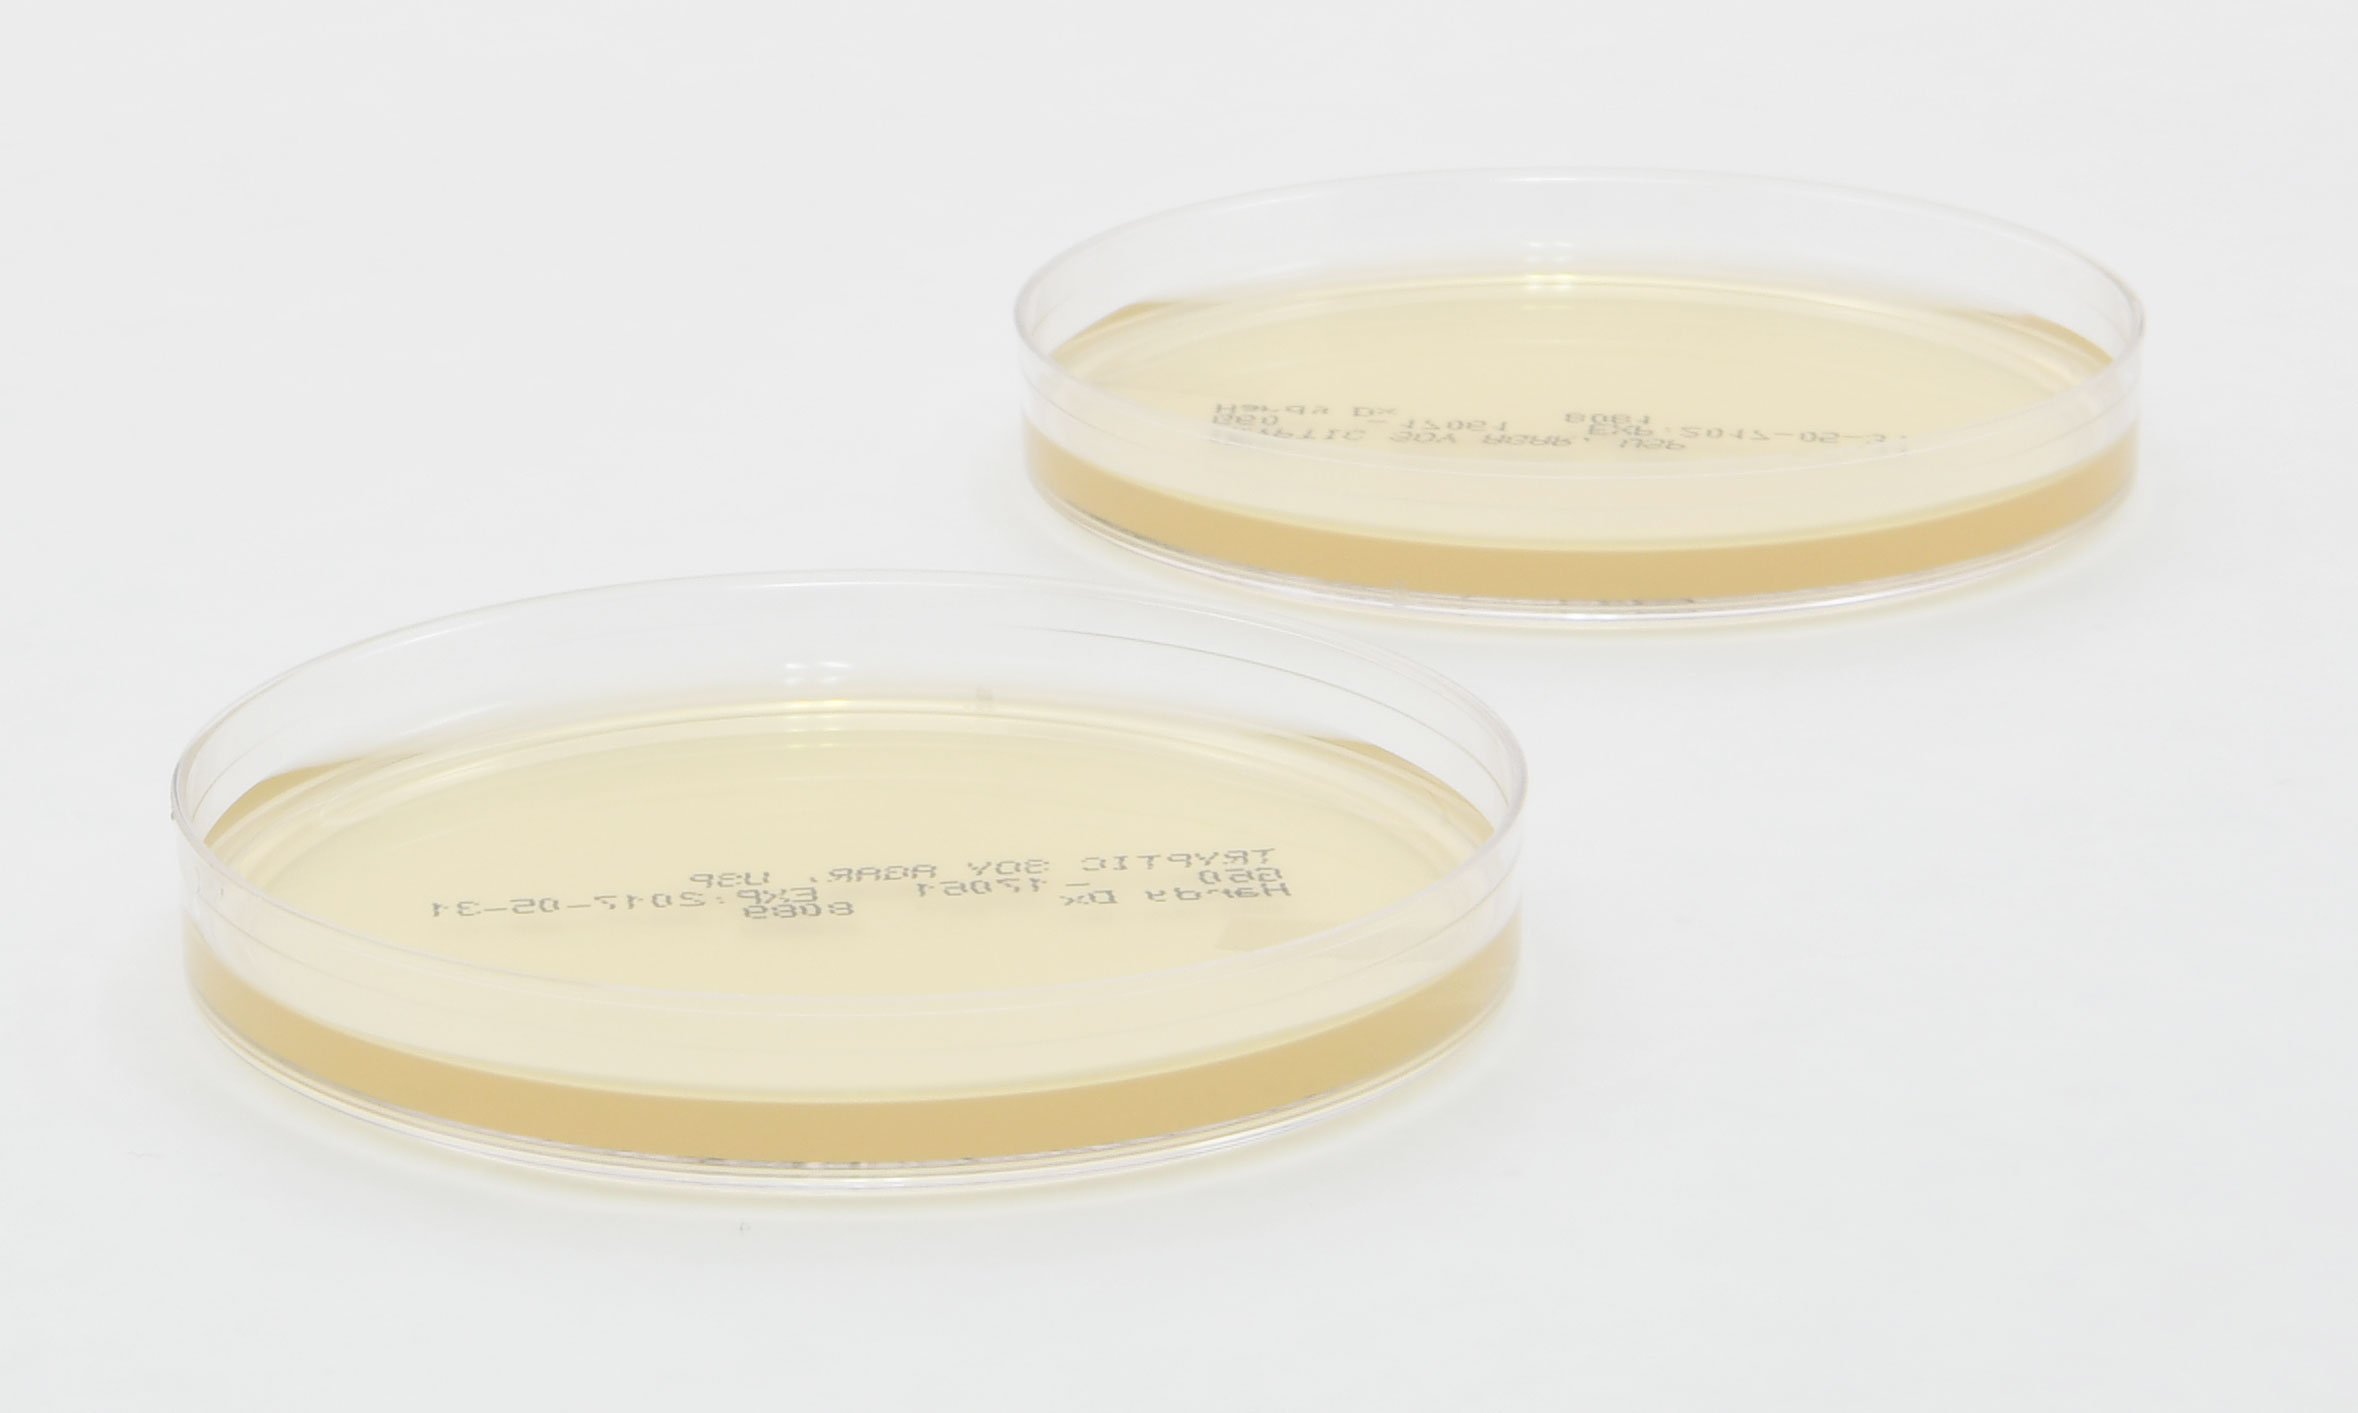
Thumbnail 7

🔬 Elevate Your Lab Game with Hardy Diagnostics!
The Hardy Diagnostics G60 Tryptic Soy Agar (TSA) plates are expertly crafted in an ISO certified facility in the USA, ensuring top-notch quality and reliability. Each pack contains 10 plates, perfect for various microbiological applications, and designed to maintain an extended shelf life.
Trustpilot
2 days ago
2 weeks ago